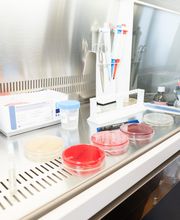
Gallery Cliente
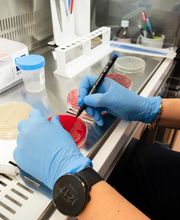
Gallery Cliente

Chiama ora!
Istituto Senese per Analisi Mediche
Ricerca
0.0(0 Recensione)
Via Aurelia Antica, 46/Scala L, 58100 Grosseto
+39056424190 (Telefono)
+39056424909 (Fax)
Novità e Offerte
Info
L'Istituto Senese di Analisi Mediche di Grosseto opera nel territorio grossetano dal 1958. È accreditato con la USL e offre ai suoi pazienti un servizio preciso e veloce con consegna dei referti, ove possibile, anche nella stessa giornata. Effettua prelievi domiciliari ed esegue esami chimico-clinici, ematologici e batteriologici. Si occupa di intolleranze alimentari e di dosaggi ormonali. Si eseguono analisi per la diagnosi precoce ed il monitoraggio del carcinoma ovarico (HE4).
Orari di apertura
- Lunedì
- 07:30 a 13:00
- Martedì
- 07:30 a 13:00
- Mercoledì
- 07:30 a 13:00
- Giovedì
- 07:30 a 13:00
- Venerdì
- 07:30 a 13:00
- Sabato
- 07:30 a 12:30
- Domenica
- Chiuso
Settori / Specializzazioni
RicercaGalleria

Mappa
Via Aurelia Antica, 46/Scala L, 58100 Grosseto
Recensione
Recensioni non verificate0.0
(0 Recensione)